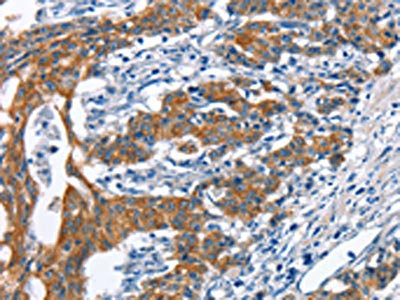

MMP2 Antibody
-
中文名稱:MMP2兔多克隆抗體
-
貨號:CSB-PA940735
-
規(guī)格:¥1100
-
圖片:
-
The image on the left is immunohistochemistry of paraffin-embedded Human gastic cancer tissue using CSB-PA940735(MMP2 Antibody) at dilution 1/60, on the right is treated with synthetic peptide. (Original magnification: ×200)
-
The image on the left is immunohistochemistry of paraffin-embedded Human cervical cancer tissue using CSB-PA940735(MMP2 Antibody) at dilution 1/60, on the right is treated with synthetic peptide. (Original magnification: ×200)
-
-
其他:
產(chǎn)品詳情
-
Uniprot No.:
-
基因名:
-
別名:72 kDa gelatinase antibody; 72kD type IV collagenase antibody; CLG 4 antibody; CLG 4A antibody; CLG4 antibody; CLG4A antibody; Collagenase Type 4 alpha antibody; Collagenase type IV A antibody; Gelatinase A antibody; Gelatinase alpha antibody; Gelatinase neutrophil antibody; Matrix metallopeptidase 2 gelatinase A 72kDa gelatinase 72kDa type IV collagenase antibody; Matrix metalloproteinase 2 (gelatinase A, 72kDa gelatinase, 72kDa type IV collagenase) antibody; Matrix Metalloproteinase 2 antibody; Matrix metalloproteinase II antibody; Matrix metalloproteinase-2 antibody; MMP 2 antibody; MMP II antibody; MMP-2 antibody; MMP2 antibody; MMP2_HUMAN antibody; MONA antibody; Neutrophil gelatinase antibody; PEX antibody; TBE 1 antibody; TBE-1 antibody
-
宿主:Rabbit
-
反應(yīng)種屬:Human,Mouse,Rat
-
免疫原:Synthetic peptide of Human MMP2
-
免疫原種屬:Homo sapiens (Human)
-
標(biāo)記方式:Non-conjugated
-
抗體亞型:IgG
-
純化方式:Antigen affinity purification
-
濃度:It differs from different batches. Please contact us to confirm it.
-
保存緩沖液:-20°C, pH7.4 PBS, 0.05% NaN3, 40% Glycerol
-
產(chǎn)品提供形式:Liquid
-
應(yīng)用范圍:ELISA,IHC
-
推薦稀釋比:
Application Recommended Dilution ELISA 1:2000-1:5000 IHC 1:50-1:200 -
Protocols:
-
儲存條件:Upon receipt, store at -20°C or -80°C. Avoid repeated freeze.
-
貨期:Basically, we can dispatch the products out in 1-3 working days after receiving your orders. Delivery time maybe differs from different purchasing way or location, please kindly consult your local distributors for specific delivery time.
-
用途:For Research Use Only. Not for use in diagnostic or therapeutic procedures.
相關(guān)產(chǎn)品
靶點(diǎn)詳情
-
功能:Ubiquitinous metalloproteinase that is involved in diverse functions such as remodeling of the vasculature, angiogenesis, tissue repair, tumor invasion, inflammation, and atherosclerotic plaque rupture. As well as degrading extracellular matrix proteins, can also act on several nonmatrix proteins such as big endothelial 1 and beta-type CGRP promoting vasoconstriction. Also cleaves KISS at a Gly-|-Leu bond. Appears to have a role in myocardial cell death pathways. Contributes to myocardial oxidative stress by regulating the activity of GSK3beta. Cleaves GSK3beta in vitro. Involved in the formation of the fibrovascular tissues in association with MMP14.; PEX, the C-terminal non-catalytic fragment of MMP2, posseses anti-angiogenic and anti-tumor properties and inhibits cell migration and cell adhesion to FGF2 and vitronectin. Ligand for integrinv/beta3 on the surface of blood vessels.; Mediates the proteolysis of CHUK/IKKA and initiates a primary innate immune response by inducing mitochondrial-nuclear stress signaling with activation of the pro-inflammatory NF-kappaB, NFAT and IRF transcriptional pathways.
-
基因功能參考文獻(xiàn):
- No significant associations were observed with either MMP-2(-1306) C/T or MMP-3(-1171) 5A/6A. PMID: 30117779
- PROK1 or MMP-2 in the amniotic fluid do not have a role in the prediction of adverse pregnancy outcomes. PMID: 29405963
- CDH17 has a role in altering MMP-2 expression via canonical NF-kappaB signalling in human gastric cancer PMID: 29783070
- Study results revealed that CCR2 promotes epithelialtomesenchymal transition through MMP2 in liver cancer. PMID: 30132565
- results of the study indicate that estradiol influence MMP-2 expression in the endometrium depends on the phase of menstrual cycle PMID: 30187906
- Fewer TIMP-2, Hsp70 and TGF-beta1 immunoreactive cells in younger individuals and increased expression of Hsp70 in elderly individuals demonstrated the influence of aging in lung remodeling PMID: 29325453
- Melatonin inhibits epithelialtomesenchymal transition in gastric cancer cells via attenuation of IL1beta/NFkappaB/MMP2/MMP9 signaling PMID: 30066836
- TF-FVIIa/trypsin-mediated PAR2 activation leads to enhanced MMP-2 expression in human breast cancer cells contributing to tumor progression. PMID: 29870887
- proteins such as MMP2 and MMP9 as well as P38 expression were also affected by the PKM2 expression changes. These results proved that PKM2 could be involved in the progression of bladder cancer by mitogen-activated protein kinases signaling pathway. PMID: 30249877
- High MMP2 expression is associated with colorectal cancer cell migration, invasion and metastasis PMID: 30015978
- We conducted a case-control genetic association study, adjusted for known IA risk factors (smoking and hypertension), in a UK Caucasian population of 1409 patients with intracranial aneurysms (IA), and 1290 matched controls, to determine the association of the rs243865 C > T functional MMP-2 gene SNP with IA (overall, and classified as ruptured and unruptured). PMID: 29334797
- MMP2 rs243865 and MMP9 rs3918242 polymorphisms are significantly associated with the risk of RSA in Chinese population. PMID: 30290617
- findings demonstrate an association between the MMP-2 C-735 T polymorphism with blood pressure and the risk of preeclampsia PMID: 29017408
- The role of MMP 2 in asthma remains unclear and no study has been conducted till date, to determine the role of MMP-2 -735C/T gene polymorphism in asthma. This study does not disprove such association. PMID: 28051223
- knockdown of TRIM31 reduced the expression of MMP2, MMP9 and phospho-Akt. PMID: 29864908
- SB22055 could reduce the expression of BSP, OPN and MMP2 in prostate cancer cells. PMID: 29917166
- Therefore, the A allele of MMP2 rs2287074 could be a protective factor for brick tea skeletal fluorosis. PMID: 28079131
- MMP-2 genetic variants are an important mediator of stroke risk PMID: 30278505
- HMGB1 promoted lung cancer invasion and metastasis by upregulating the expression and activity of MMP-2 in an NF-kappaB-dependent manner. PMID: 29850505
- High glucose levels induce MMP-2 expression in Human cardiac fibroblasts , possibly by up-regulation of SGLT1. PMID: 29512713
- we have discovered the novel N-72, and it was crucial for EGF-induced migration by targeting MMP2 in Human amnion mesenchymal stem cells (hAMSCs) PMID: 29734654
- data indicated that MMP-2/MMP-9 was coordinately targeted by two non-coding RNAs, miR-296-3p and FOXCUT, which were decreased, and tumor-suppressing factors in choroidal malignant melanoma PMID: 29260433
- Increased MMP-2 and MMP-9 activities may contribute to the pathogenesis and disease severity of cutaneous lupus erythematosus. PMID: 29349515
- No association between the carriage of studied MMP2 polymorphisms and the predisposition to preeclampsia was found. PMID: 29670668
- We propose that serum levels of MMP-2 and MMP-9 are not predictive on treatment response and survival in LARC patients. PMID: 29578156
- that miR-338-5p has a function in promoting glioma cell invasion by targeting TSHZ3 suppression on MMP2 PMID: 28780604
- In dilation cardiomyopathy, expression of MMP-2, MMP-9, and TIMP-1 and their ratios in autopsy material and in cultures was elevated by 1.5-9 times. PMID: 29504111
- OSM [oncostatin M]might be involved in the invasiveness of extravillous trophoblasts under hypoxia conditions via increasing MMP-2 and MMP-9 enzymatic activities through STAT3 signaling. Increased MMP-9 activity by OSM seems to be more important in primary trophoblasts. PMID: 30091322
- TIMP2 promotes tumor progression and miR2055p directly regulates TIMP2, thereby suppressing proMMP2 activation and inhibiting oral squamous cell carcinoma cell invasiveness. PMID: 29393341
- Elevated MMP-2 levels were observed in blood of pancreatic cancer patients which correlated with its tissue expression. However, these levels did not associate with survival or any clinicopathological parameters of patients. PMID: 29355139
- Increased urinary concentration of matrix metallopeptidase 2 (MMP-2) at 12 and 16 weeks of gestation predicted an increased risk of developing preeclampsia in the study population. PMID: 28055277
- There was no difference found in MMP-2, MMP-9 or TLR-4 levels between non-thrombocytopenic and thrombocytopenic septic donors. PLA formation was increased in thrombocytopenic patients. PMID: 29734352
- MMP2 rs243865 was the only single nucleotide polymorphism significantly associated with Floppy Mitral Valve/Mitral Valve Prolapse (FMV/MVP) as compared to the control.The frequency of certain MMP2 polymorphisms is higher in patients with the FMV/MVP syndrome and patients with FMV/MVP without the syndrome. PMID: 28750369
- Platelets may contribute to joint degeneration in knee osteoarthritis by favouring the accumulation of MMP-2 in synovial fluid. PMID: 28981555
- In pregnancy MMP2 gene expression was significantly higher in preterm than full term. Human papilloma viral load was found to be positively correlated to the rate of MMP2 expression and the gestational age was significantly related to the viral load and the rate of expression of MMP2 gene. Human pabilloma virus especially high-risk genotypes was correlated to spontaneous preterm labor in Egyptian females. PMID: 28264621
- We conclude that S1P attenuates the invasion of C643 cells by activating S1P2 and the Rho-ROCK pathway, by decreasing calpain activity, and by decreasing the expression, secretion and activity of MMP2 and, to a lesser extent, MMP9. Our results thus unveil a novel function for the S1P2 receptor in attenuating thyroid cancer cell invasion. PMID: 29734379
- High mmp2 expression is associated with ovarian cancer cell migration and invasion. PMID: 28677781
- MMP-2 was expressed in high percentage of endometrial cancer and its expression may be associated closely with clinical stage, and tumor invasion and metastasis, indicating that MMP-2 overexpression may serve as a predictive factor for poor prognosis of endometrial cancer. PMID: 30024495
- MMP2 single nucleotide polymorphisms association with lymphedema caused by Wuchereria bancrofti. PMID: 29122006
- MMP-2 promoted and MMP-13 disrupted vasculogenic mimicry formation in large cell lung cancer by cleaving laminin-5 to influence EGFR signal activation. PMID: 28766880
- Data suggest that environmental carcinogen PFOA (perfluorooctanoic acid) stimulates ovarian cancer cell migration, invasion, and MMP2/MMP9 expression by up-regulating ERK/NFkappaB signaling pathway. (MMP = matrix metallopeptidase; NFkappaB = nuclear factor kappa B) PMID: 29753068
- Matrix-metalloproteinase-2 is implicated in the pathophysiological mechanism of stenosis development and has a predictive value for arteriovenous fistula failure in hemodialysis patients PMID: 28868755
- Fli1 functioned as an oncogene in HCC carcinogenesis and it exerted its promoting metastatic effect primarily by modulating the matrix metalloproteinase (MMP)2 signaling pathway. PMID: 29138848
- Rictor regulates the vasculogenic mimicry of melanoma and determines the patients' survival via the AKT-MMP2-MMP9 pathway. PMID: 28699701
- Expression of BRM and MMP2 in the thoracic aortic aneurysm and aortic dissection is very high, indicating that BRM and MMP2 may play important roles in the occurrence and development of thoracic aortic aneurysm and aortic dissection. PMID: 28678310
- at high endothelial shear stress, PI16 contributes to inhibition of MMP2 protease activity, protection that can be reversed during inflammation PMID: 27996045
- MMP-2 serum level and circulating tumor cells show the potential to predict CNS metastases and overall survival in breast cancer patients; CTCs and MMP-9 serum level could be a promising therapy response marker in castration resistant prostate cancer patients PMID: 28529342
- RhoGDIbeta overexpression led to downregulation of miR-200c, whereas miR-200c was able directly to target 3'-UTR of jnk2mRNA and attenuated JNK2 protein translation, which resulted in attenuation of Sp1mRNA and protein expression in turn, inhibiting Sp1-dependent MMP-2 transcription. PMID: 28846829
- both HBEGF upregulation and apoptosis were rescued by exogenous MMP2 PMID: 28731464
- MMP-2 (and MMP-1 and MMP-3) are independently associated with markers of arterial stiffening in patients with type 1 diabetes. PMID: 29070037
顯示更多
收起更多
-
相關(guān)疾病:Multicentric osteolysis, nodulosis, and arthropathy (MONA)
-
亞細(xì)胞定位:[Isoform 1]: Secreted, extracellular space, extracellular matrix. Membrane. Nucleus. Note=Colocalizes with integrin alphaV/beta3 at the membrane surface in angiogenic blood vessels and melanomas. Found in mitochondria, along microfibrils, and in nuclei of cardiomyocytes.; [Isoform 2]: Cytoplasm. Mitochondrion.
-
蛋白家族:Peptidase M10A family
-
組織特異性:Produced by normal skin fibroblasts. PEX is expressed in a number of tumors including gliomas, breast and prostate.
-
數(shù)據(jù)庫鏈接:
Most popular with customers
-
-
YWHAB Recombinant Monoclonal Antibody
Applications: ELISA, WB, IHC, IF, FC
Species Reactivity: Human, Mouse, Rat
-
Phospho-YAP1 (S127) Recombinant Monoclonal Antibody
Applications: ELISA, WB, IHC
Species Reactivity: Human
-
-
-
-
-